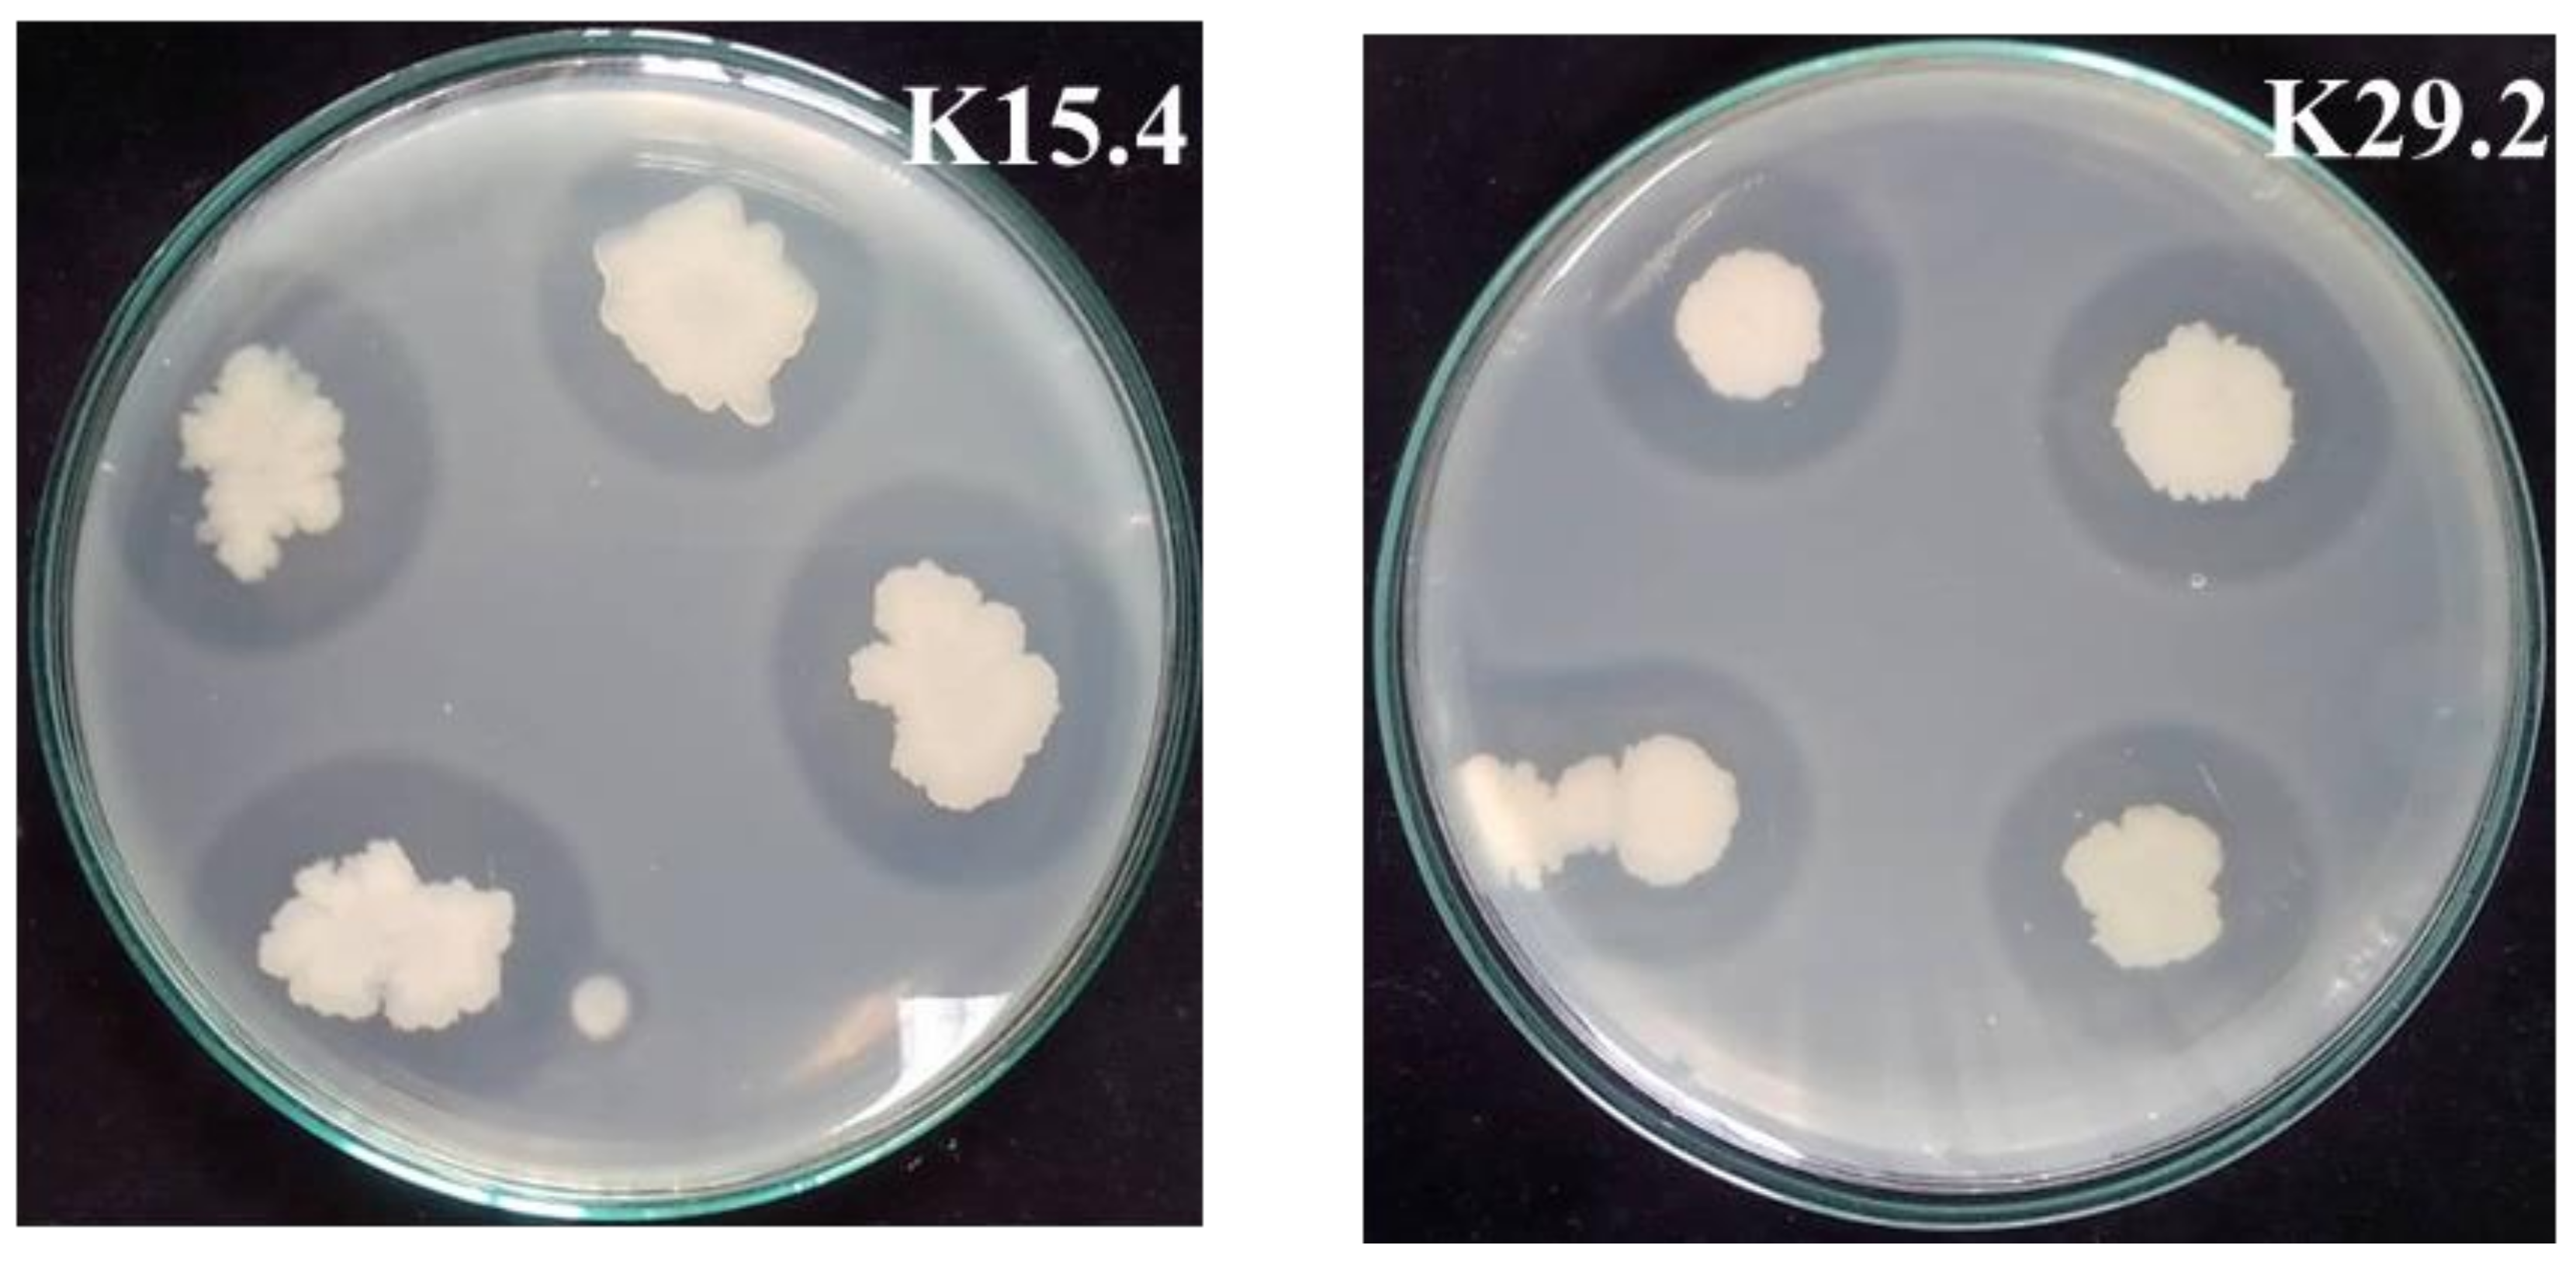
Microorganisms 12 01687 g006

Bacillus spp. Isolated from Miang as Potential Probiotics in Nile Tilapia Culture—In Vitro Research
Abstract
1. Introduction
2. Materials and Methods
2.1. Bacterial Strains and Culture Condition
2.2. Screening for Bacillus Strain with Antimicrobial Activity against Fish Pathogens
2.3. Bacteriocin Producing Test by Agar-Well Diffusion Assay
2.4. Acid and Bile Salt Tolerance Tests
2.5. Molecular Identification and Phylogenetic Analysis
2.6. Antibiotic Susceptibility Test of the Selected Bacillus Species
2.7. Time Course Study of Growth and Antimicrobial Activity of the Selected Strains
2.8. Tannin Tolerance Ability Test
2.9. Protease-Producing Capability of Selected Bacillus Strains
2.10. Polysaccharide Degrading Enzymes Producing Capability of Selected Bacillus Strains
2.11. In Vitro Evaluation of Polysaccharases and Proteases Activities against Fish Feed Substrate
2.12. Statistical Analysis
3. Results and Discussion
3.1. Screening of Anti-Fish Pathogen Bacillus Strain by Soft Agar Overlay Technique
3.2. Bacteriocin-Producing Test by Agar-Well Diffusion Assay
3.3. Acid and Bile Salt Tolerances Test
3.4. Bacterial Identification and Phylogenetic Relationships
3.5. Antibiotic Susceptibility Profile of the Potential Probiotic Bacillus Species
3.6. Time Course of Growth and Antimicrobial Activity of the Selected Strains
3.7. Proteolytic Activity of the Bacillus Species
3.8. Polysaccharide Degrading Enzyme Production of the Selected Bacillus Species
3.9. Tannin Tolerance Determination
3.10. Evaluation of Polysaccharases and Proteases Activities on Feed Polysaccharides and Proteins
4. Conclusions
Author Contributions
Funding
Data Availability Statement
Acknowledgments
Conflicts of Interest
References
- Howell, R. Types of bacterial pathogens in aquaculture. Fish Aquac. J. 2022, 13, 301. [Google Scholar]
- Delphino, M.K.V.C.; Leal, C.A.G.; Gardner, I.A.; Assis, G.B.N.; Roriz, G.D.; Ferreira, F.; Figueiredo, H.C.P.; Gonçalves, V.S.P. Seasonal dynamics of bacterial pathogens of Nile tilapia farmed in a Brazilian reservoir. Aquaculture 2019, 498, 100–108. [Google Scholar] [CrossRef]
- Haenen, O.L.M.; Dong, H.T.; Hoai, T.D.; Crumlish, M.; Karunasagar, I.; Barkham, T.; Chen, S.L.; Zadoks, R.; Kiermeier, A.; Wang, B.; et al. Bacterial diseases of tilapia, their zoonotic potential and risk of antimicrobial resistance. Rev. Aquac. 2023, 15, 154–185. [Google Scholar] [CrossRef]
- Rodkhum, C.; Kayansamruaj, P.; Pirarat, N. Effect of water temperature on susceptibility to Streptococcus agalactiae serotype Ia infection in Nile tilapia (Oreochromis niloticus). Thai J. Vet. Med. 2011, 41, 309–314. [Google Scholar] [CrossRef]
- Semwal, A.; Kumar, A.; Kumar, N. A review on pathogenicity of Aeromonas hydrophila and their mitigation through medicinal herbs in aquaculture. Heliyon 2023, 9, e14088. [Google Scholar] [CrossRef] [PubMed]
- Figueras, M.J.; Alperi, A.; Saavedra, M.J.; Ko, W.C.; Gonzalo, N.; Navarro, M.; Martínez-Murcia, A.J. Clinical relevance of the recently described species Aeromonas aquariorum. J. Clin. Microbiol. 2009, 47, 3742. [Google Scholar] [CrossRef] [PubMed]
- Abdullah, S.; Omar, N.; Yusoff, S.M.; Obukwho, E.B.; Nwunuji, T.P.; Hanan, L.; Samad, J. Clinicopathological features and immunohistochemical detection of antigens in acute experimental Streptococcus agalactiae infection in red tilapia (Oreochromis spp.). SpringerPlus 2013, 2, 286. [Google Scholar] [CrossRef]
- Haridas, V.D.; Joshy, C.G.; Pillai, D. Optimization of the multispecies probiotic combination with N-acylhomoserine lactone-degrading ability for increased disease resistance of Carassius auratus using response surface methodology. Aquaculture 2022, 548, 737597. [Google Scholar] [CrossRef]
- Patil, H.J.; Benet-Perelberg, A.; Naor, A.; Smirnov, M.; Ofek, T.; Nasser, A.; Minz, D.; Cytryn, E. Evidence of increased antibiotic resistance in phylogenetically-diverse Aeromonas isolates from semi-intensive fish ponds treated with antibiotics. Front. Microbiol. 2016, 7, 1875. [Google Scholar] [CrossRef]
- Cavalcante, R.B.; Telli, G.S.; Tachibana, L.; Dias, D.d.C.; Oshiro, E.; Natori, M.M.; Silva, W.F.d.; Ranzani-Paiva, M.J. Probiotics, prebiotics and synbiotics for Nile tilapia: Growth performance and protection against Aeromonas hydrophila infection. Aquac. Rep. 2020, 17, 100343. [Google Scholar] [CrossRef]
- Cabello, F.C. Heavy use of prophylactic antibiotics in aquaculture: A growing problem for human and animal health and for the environment. Environ. Microbiol. 2006, 8, 1137–1144. [Google Scholar] [CrossRef] [PubMed]
- Sommanustweechai, A.; Chanvatik, S.; Sermsinsiri, V.; Sivilaikul, S.; Patcharanarumol, W.; Yeung, S.; Tangcharoensathien, V. Antibiotic distribution channels in Thailand: Results of key-informant interviews, reviews of drug regulations and database searches. Bull. World Health Organ. 2018, 96, 101. [Google Scholar] [CrossRef] [PubMed]
- Vincent, A.T.; Gauthier, J.; Derome, N.; Charette, S.J. The rise and fall of antibiotics in aquaculture. In Microbial Communities in Aquaculture Ecosystems; Springer: Berlin/Heidelberg, Germany, 2019; pp. 1–19. [Google Scholar]
- Lulijwa, R.; Rupia, E.J.; Alfaro, A.C. Antibiotic use in aquaculture, policies and regulation, health and environmental risks: A review of the top 15 major producers. Rev. Aquac. 2020, 12, 640–663. [Google Scholar] [CrossRef]
- Oliveira, L.M.A.; Simões, L.C.; Costa, N.S.; Zadoks, R.N.; Pinto, T.C.A. The landscape of antimicrobial resistance in the neonatal and multi-host pathogen group B Streptococcus: Review from a One Health perspective. Front. Microbiol. 2022, 13, 943413. [Google Scholar] [CrossRef] [PubMed]
- Smith, J.T.; Lewin, C.S. Mechanisms of antimicrobial resistance and implications for epidemiology. Vet. Microbiol. 1993, 35, 233–242. [Google Scholar] [CrossRef] [PubMed]
- Yang, Y.; Kuang, X.; Han, R.-J.; Zhai, Y.-J.; He, D.-D.; Zhao, J.-F.; Liu, J.-H.; Hu, G.-Z. Characterization of a novel linezolid resistance gene optrA and bacitracin resistance locus-carrying multiple antibiotic resistant integrative and conjugative element ICE Ssu 1112S in Streptococccus suis. Microbiol. Spectr. 2022, 10, e0196321. [Google Scholar] [CrossRef] [PubMed]
- Sumpradit, N.; Wongkongkathep, S.; Malathum, K.; Janejai, N.; Paveenkittiporn, W.; Yingyong, T.; Chuxnum, T.; Vijitleela, A.; Boonyarit, P.; Akaleephan, C. Thailand’s national strategic plan on antimicrobial resistance: Progress and challenges. Bull. World Health Organ. 2021, 99, 661. [Google Scholar] [CrossRef] [PubMed]
- Altimira, F.; Godoy, S.; Arias-Aravena, M.; Araya, B.; Montes, C.; Castro, J.F.; Dardón, E.; Montenegro, E.; Pineda, W.; Viteri, I.; et al. Genomic and experimental analysis of the biostimulant and antagonistic properties of phytopathogens of Bacillus safensis and Bacillus siamensis. Microorganisms 2022, 10, 670. [Google Scholar] [CrossRef] [PubMed]
- Gao, J.; Yu, F.Q.; Luo, L.P.; He, J.Z.; Hou, R.G.; Zhang, H.Q.; Li, S.M.; Su, J.L.; Han, B. Antibiotic resistance of Streptococcus agalactiae from cows with mastitis. Vet. J. 2012, 194, 423–424. [Google Scholar] [CrossRef] [PubMed]
- Roges, E.M.; Gonçalves, V.D.; Cardoso, M.D.; Festivo, M.L.; Siciliano, S.; Berto, L.H.; de Almeida Pereira, V.L.; dos Prazeres Rodrigues, D.; de Aquino, M.H.C. Virulence-associated genes and antimicrobial resistance of Aeromonas hydrophila isolates from animal, food, and human sources in Brazil. BioMed Res. Int. 2020, 2020, 1052607. [Google Scholar] [CrossRef] [PubMed]
- FAO; WHO. Probiotics in food health and nutritional properties and guidelines for evaluation. FAO Food Nutr. Pap. 2006, 85, 1–56. [Google Scholar]
- Merrifield, D.L.; Dimitroglou, A.; Foey, A.; Davies, S.J.; Baker, R.T.M.; Bøgwald, J.; Castex, M.; Ringø, E. The current status and future focus of probiotic and prebiotic applications for salmonids. Aquaculture 2010, 302, 1–18. [Google Scholar] [CrossRef]
- Ayivi, R.D.; Gyawali, R.; Krastanov, A.; Aljaloud, S.O.; Worku, M.; Tahergorabi, R.; da Silva, R.C.; Ibrahim, S.A. Lactic acid bacteria: Food safety and human health applications. Dairy 2020, 1, 202–232. [Google Scholar] [CrossRef]
- Cruz, P.M.; Ibáñez, A.L.; Hermosillo, O.A.M.; Saad, H.C.R. Use of probiotics in aquaculture. ISRN Microbiol. 2012, 2012, 916845. [Google Scholar]
- Opiyo, M.A.; Jumbe, J.; Ngugi, C.C.; Charo-Karisa, H. Different levels of probiotics affect growth, survival and body composition of Nile tilapia (Oreochromis niloticus) cultured in low input ponds. Sci. Afr. 2019, 4, e00103. [Google Scholar] [CrossRef]
- Unban, K.; Kodchasee, P.; Shetty, K.; Khanongnuch, C. Tannin-tolerant and extracellular tannase producing Bacillus isolated from traditional fermented tea leaves and their probiotic functional properties. Foods 2020, 9, 490. [Google Scholar] [CrossRef] [PubMed]
- Van Hai, N. Research findings from the use of probiotics in tilapia aquaculture: A review. Fish Shellfish Immunol. 2015, 45, 592–597. [Google Scholar]
- Kuebutornye, F.K.; Abarike, E.D.; Lu, Y. A review on the application of Bacillus as probiotics in aquaculture. Fish Shellfish Immunol. 2019, 87, 820–828. [Google Scholar] [CrossRef] [PubMed]
- Anyairo, C.S.; Unban, K.; Shetty, K.; Khanongnuch, C. Bacteriocin producing Bacillus and their potential applications in fish farming. Int. Aquat. Res. 2024, 16, 17–37. [Google Scholar]
- Silva, T.F.A.; Petrillo, T.R.; Yunis-Aguinaga, J.; Marcusso, P.F.; da Silva Claudiano, G.; de Moraes, F.R.; de Moraes, J.R.E. Effects of the probiotic Bacillus amyloliquefaciens on growth performance, hematology and intestinal morphometry in cage-reared Nile tilapia. Lat. Am. J. Aquat. Res. 2015, 43, 963–971. [Google Scholar] [CrossRef]
- Maas, R.M.; Verdegem, M.C.; Stevens, T.L.; Schrama, J.W. Effect of exogenous enzymes (phytase and xylanase) supplementation on nutrient digestibility and growth performance of Nile tilapia (Oreochromis niloticus) fed different quality diets. Aquaculture 2020, 529, 735723. [Google Scholar] [CrossRef]
- Maas, R.M.; Verdegem, M.C.; Debnath, S.; Marchal, L.; Schrama, J.W. Effect of enzymes (phytase and xylanase), probiotics (B. amyloliquefaciens) and their combination on growth performance and nutrient utilisation in Nile tilapia. Aquaculture 2021, 533, 736226. [Google Scholar] [CrossRef]
- Bravo, L.; Serradell, J.; Montero, A.; Gómez-Mercader, D.; Acosta, A.; Monzón-Atienza, L.; Bravo, J.; Serradell, A.; Montero, D.; Gómez-Mercader, A.; et al. Current status of probiotics in European Sea bass aquaculture as one important Mediterranean and Atlantic commercial species: A review. Animals 2023, 13, 2369. [Google Scholar] [CrossRef]
- Talukder Shefat, S.H. Probiotic strains used in aquaculture. Int. Res. J. Microbiol. 2018, 7, 43–55. [Google Scholar] [CrossRef]
- Hassaan, M.S.; Mohammady, E.Y.; Soaudy, M.R.; Elashry, M.A.; Moustafa, M.M.A.; Wassel, M.A.; El-Garhy, H.A.S.; El-Haroun, E.R.; Elsaied, H.E. Synergistic effects of Bacillus pumilus and exogenous protease on Nile tilapia (Oreochromis niloticus) growth, gut microbes, immune response and gene expression fed plant protein diet. Anim. Feed Sci. Technol. 2021, 275, 114892. [Google Scholar] [CrossRef]
- Saputra, F.; Shiu, Y.L.; Chen, Y.C.; Puspitasari, A.W.; Danata, R.H.; Liu, C.H.; Hu, S.Y. Dietary supplementation with xylanase-expressing B. amyloliquefaciens R8 improves growth performance and enhances immunity against Aeromonas hydrophila in Nile tilapia (Oreochromis niloticus). Fish Shellfish Immunol. 2016, 58, 397–405. [Google Scholar] [CrossRef] [PubMed]
- Shija, V.M.; Amoah, K.; Cai, J. Effect of Bacillus probiotics on the immunological responses of Nile tilapia (Oreochromis niloticus): A Review. Fishes 2023, 8, 366. [Google Scholar] [CrossRef]
- Unban, K.; Khatthongngam, N.; Pattananandecha, T.; Saenjum, C.; Shetty, K.; Khanongnuch, C. Microbial community dynamics during the non-filamentous fungi growth-based fermentation process of Miang, a traditional fermented tea of north Thailand and their product characterizations. Front. Microbiol. 2020, 11, 1515. [Google Scholar] [CrossRef]
- Hockett, K.L.; Baltrus, D.A. Use of the Soft-agar overlay technique to screen for bacterially produced inhibitory compounds. J. Vis. Exp. JoVE 2017, 2017, 55064. [Google Scholar]
- Tagg, J.R.; McGiven, A.R. Assay system for bacteriocins. Appl. Microbiol. 1971, 21, 943. [Google Scholar] [CrossRef]
- Sharma, N.; Kapoor, R.; Gautam, N.; Kumari, R. Purification and characterization of bacteriocin produced by Bacillus subtilis R75 isolated from fermented chunks of Mung bean (Phaseolus radiatus). Food Technol. Biotechnol. 2011, 49, 169. [Google Scholar]
- Hudzicki, J. Kirby-Bauer disk diffusion susceptibility test protocol. Am. Soc. Microbiol. 2009, 15, 55–63. [Google Scholar]
- CLSI. Methods for Dilution Antimicrobial Susceptibility Tests for Bacteria That Grow Aerobically, 11th ed.; Clinical Laboratory Science Institute: Berwyn, PA, USA, 2018; Volume 38, pp. 1–62. [Google Scholar]
- Xin, B.; Xu, H.; Liu, H.; Liu, S.; Wang, J.; Xue, J.; Zhang, F.; Deng, S.; Zeng, H.; Zeng, X.; et al. Identification and characterization of a novel circular bacteriocin, bacicyclicin XIN-1, from Bacillus sp. Xin1. Food Control. 2021, 121, 107696. [Google Scholar] [CrossRef]
- Choi, G.H.; Fugaban, J.I.I.; Dioso, C.M.; Bucheli, J.E.V.; Holzapfel, W.H.; Todorov, S.D. Selection of bacteriocinogenic Bacillus spp. from traditional fermented Korean food products with additional beneficial properties. Fermentation 2021, 7, 271. [Google Scholar] [CrossRef]
- Kanpiengjai, A.; Nguyen, T.-H.; Haltrich, D.; Khanongnuch, C. Expression and comparative characterization of complete and C-terminally truncated forms of saccharifying α-amylase from Lactobacillus plantarum S21. Int. J. Biol. Macromol. 2017, 103, 1294–1301. [Google Scholar] [CrossRef] [PubMed]
- Kanpiengjai, A.; Chui-Chai, N.; Chaikaew, S.; Khanongnuch, C. Distribution of tannin-tolerant yeasts isolated from Miang, a traditional fermented tea leaf (Camellia sinensis var. assamica) in northern Thailand. Int. J. Food Microbiol. 2016, 238, 121–131. [Google Scholar] [CrossRef] [PubMed]
- Khatthongngam, N.; Watina, N.; Unban, K.; Phongthai, S.; Khanongnuch, C. A selected β-mannanase producing bacilli capable of miang extract tolerant isolated from traditional fermented tea leaf from north thailand. Food App. Biosci. J. 2019, 7, 1–16. [Google Scholar]
- Miller, G.L. Use of dinitrosalicylic acid reagent for determination of reducing sugar. Anal. Chem. 1959, 31, 426–428. [Google Scholar] [CrossRef]
- Martínez, F.P.; Bermúdez, L.; Aznar, M.J.; Moyano, F.J. Evaluation of enzyme additives on the nutritional use of feeds with a high content of plant ingredients for Mugil cephalus. Fishes 2019, 4, 56. [Google Scholar] [CrossRef]
- Lim, K.B.; Balolong, M.P.; Kim, S.H.; Oh, J.K.; Lee, J.Y.; Kang, D.K. Isolation and characterization of a broad spectrum bacteriocin from Bacillus amyloliquefaciens RX7. BioMed Res. Int. 2016, 2016, 8521476. [Google Scholar] [CrossRef] [PubMed]
- Marco, M.L.; Sanders, M.E.; Gänzle, M.; Arrieta, M.C.; Cotter, P.D.; De Vuyst, L.; Hill, C.; Holzapfel, W.; Lebeer, S.; Merenstein, D.; et al. The International Scientific Association for Probiotics and Prebiotics (ISAPP) consensus statement on fermented foods. Nat. Rev. Gastroenterol. Hepatol. 2021, 18, 196–208. [Google Scholar] [CrossRef] [PubMed]
- Bowen, S.H. The biology and culture of tilapias. In Proceedings of the International Conference on the Biology and Culture of Tilapias, Study and Conference Center of the Rockefeller Foundation, Bellagio, Italy, 2–5 September 1980; pp. 141–156. [Google Scholar]
- Balcázar, J.L.; Vendrell, D.; de Blas, I.; Ruiz-Zarzuela, I.; Muzquiz, J.L.; Girones, O. Characterization of probiotic properties of lactic acid bacteria isolated from intestinal microbiota of fish. Aquaculture 2008, 278, 188–191. [Google Scholar] [CrossRef]
- Jiang, M.; Wen, H.; Gou, G.; Liu, T.; Lu, X.; Deng, D. Preliminary study to evaluate the effects of dietary bile acids on growth performance and lipid metabolism of juvenile genetically improved farmed tilapia (Oreochromis niloticus) fed plant ingredient-based diets. Aquac. Nutr. 2018, 24, 1175–1183. [Google Scholar] [CrossRef]
- Kortner, T.M.; Gu, J.; Krogdahl, Å.; Bakke, A.M. Transcriptional regulation of cholesterol and bile acid metabolism after dietary soyabean meal treatment in Atlantic salmon (Salmo salar L.). Br. J. Nutr. 2013, 109, 593–604. [Google Scholar] [CrossRef] [PubMed]
- Thompson, C.C.; Chimetto, L.; Edwards, R.A.; Swings, J.; Stackebrandt, E.; Thompson, F.L. Microbial genomic taxonomy. BMC Genom. 2013, 14, 913. [Google Scholar] [CrossRef] [PubMed]
- Gatson, J.W.; Benz, B.F.; Chandrasekaran, C.; Satomi, M.; Venkateswaran, K.; Hart, M.E. Bacillus tequilensis sp. nov., isolated from a 2000-year-old Mexican shaft-tomb, is closely related to Bacillus subtilis. Int. J. Syst. Evol. Microbiol. 2006, 56, 1475–1484. [Google Scholar] [CrossRef] [PubMed]
- Guerrero-Barajas, C.; Constantino-Salinas, E.A.; Amora-Lazcano, E.; Tlalapango-Ángeles, D.; Mendoza-Figueroa, J.S.; Cruz-Maya, J.A.; Jan-Roblero, J. Bacillus mycoides A1 and Bacillus tequilensis A3 inhibit the growth of a member of the phytopathogen Colletotrichum gloeosporioides species complex in avocado. J. Sci. Food Agric. 2020, 100, 4049–4056. [Google Scholar] [CrossRef] [PubMed]
- Karunasagar, I.; Karunasagar, I.; Bondad-Reantaso, M.G. Complexities involved in source attribution of antimicrobial resistance genes found in aquaculture products. Asian Fish. Sci. 2020, 33, 16–21. [Google Scholar] [CrossRef]
- Adimpong, D.B.; Nielsen, D.S.; Sørensen, K.I.; Derkx, P.M.F.; Jespersen, L. Genotypic characterization and safety assessment of lactic acid bacteria from indigenous African fermented food products. BMC Microbiol. 2012, 12, 75. [Google Scholar] [CrossRef]
- Gueimonde, M.; Sánchez, B.; de los Reyes-Gavilán, C.G.; Margolles, A. Antibiotic resistance in probiotic bacteria. Front. Microbiol. 2013, 4, 202. [Google Scholar] [CrossRef] [PubMed]
- Rani, R.P.; Anandharaj, M.; Hema, S.; Deepika, R.; Ravindran, A.D. Purification of antilisterial peptide (Subtilosin A) from novel Bacillus tequilensis FR9 and demonstrate their pathogen invasion protection ability using human carcinoma cell line. Front. Microbiol. 2016, 7, 226698. [Google Scholar]
- Meidong, R.; Doolgindachbaporn, S.; Jamjan, W.; Sakai, K.; Tashiro, Y.; Okugawa, Y.; Tongpim, S. A novel probiotic Bacillus siamensis B44v isolated from Thai pickled vegetables (Phak-dong) for potential use as a feed supplement in aquaculture. J. Gen. Appl. Microbiol. 2017, 63, 246–253. [Google Scholar] [CrossRef]
- Schleifer, K.H. Phylum XIII. Firmicutes. In Bergey’s Manual of Systematic Bacteriology, 2nd ed.; Springer: New York, NY, USA, 2009; Volume 3, pp. 20–193. [Google Scholar]
- Simons, A.; Alhanout, K.; Duval, R.E. Bacteriocins, antimicrobial peptides from bacterial origin: Overview of their biology and their impact against multidrug-resistant bacteria. Microorganisms 2020, 8, 639. [Google Scholar] [CrossRef] [PubMed]
- Zangeneh, M.; Khorrami, S.; Khaleghi, M. Bacteriostatic activity and partial characterization of the bacteriocin produced by L. plantarum sp. isolated from traditional sourdough. Food Sci. Nutr. 2020, 8, 6023–6030. [Google Scholar] [CrossRef] [PubMed]
- Darbandi, A.; Asadi, A.; Mahdizade Ari, M.; Ohadi, E.; Talebi, M.; Halaj Zadeh, M.; Darb Emamie, A.; Ghanavati, R.; Kakanj, M. Bacteriocins: Properties and potential use as antimicrobials. J. Clin. Lab. Anal. 2022, 36, e24093. [Google Scholar] [CrossRef] [PubMed]
- Razzaq, A.; Shamsi, S.; Ali, A.; Ali, Q.; Sajjad, M.; Malik, A.; Ashraf, M. Microbial proteases applications. Front. Bioeng. Biotechnol. 2019, 7, 110. [Google Scholar] [CrossRef] [PubMed]
- Velázquez-De Lucio, B.S.; Hernández-Domínguez, E.M.; Villa-García, M.; Díaz-Godínez, G.; Mandujano-Gonzalez, V.; Mendoza-Mendoza, B.; Álvarez-Cervantes, J. Exogenous enzymes as zootechnical additives in animal feed: A review. Catalysts 2021, 11, 851. [Google Scholar] [CrossRef]
- Thurlow, C.M.; Williams, M.A.; Carrias, A.; Ran, C.; Newman, M.; Tweedie, J.; Allison, E.; Jescovitch, L.N.; Wilson, A.E.; Terhune, J.S.; et al. Bacillus velezensis AP193 exerts probiotic effects in channel catfish (Ictalurus punctatus) and reduces aquaculture pond eutrophication. Aquaculture 2019, 503, 347–356. [Google Scholar] [CrossRef]
- Zhao, C.; Men, X.; Dang, Y.; Zhou, Y.; Ren, Y. Probiotics mediate intestinal microbiome and microbiota-derived metabolites regulating the growth and immunity of Rainbow trout (Oncorhynchus mykiss). Microbiol. Spectr. 2023, 11, e0398022. [Google Scholar] [CrossRef] [PubMed]
- Sharma, A.; Tewari, R.; Soni, K. Application of statistical approach for optimizing CMCase production by Bacillus tequilensis s28 strain via submerged fermentation using wheat bran as carbon source. Int. J. Biotechnol. Bioeng. 2015, 9, 1–11. [Google Scholar]
- Ye, M.; Sun, L.; Yang, R.; Wang, Z.; Qi, K. The optimization of fermentation conditions for producing cellulase of Bacillus amyloliquefaciens and its application to goose feed. R. Soc. Open Sci. 2017, 4, 171012. [Google Scholar] [CrossRef] [PubMed]
- Khianngam, S.; Pootaeng-on, Y.; Techakriengkrai, T.; Tanasupawat, S. Screening and identification of cellulase producing bacteria isolated from oil palm meal. J. Appl. Pharm. Sci. 2014, 4, 090–096. [Google Scholar]
- You, W.; Ge, C.; Jiang, Z.; Chen, M.; Li, W.; Shao, Y. Screening of a broad-spectrum antagonist-Bacillus siamensis, and its possible mechanisms to control postharvest disease in tropical fruits. Biol. Control 2021, 157, 104584. [Google Scholar] [CrossRef]
- Yopi, Y.; Djohan, A.C.; Rahmani, N.; Jannah, A.M. Isolation and characterization of mannanase, xylanase, and cellulase from marine bacteria Bacillus sp. Biofarmasi J. Nat. Prod. Biochem. 2017, 15, 15–20. [Google Scholar] [CrossRef]
- Tesfahun, A.; Temesgen, M. Food and feeding habits of Nile tilapia Oreochromis niloticus (L.) in Ethiopian water bodies: A review. Int. J. Fish. Aquat. 2018, 6, 43–47. [Google Scholar]
- Francis, G.; Makkar, H.P.S.; Becker, K. Antinutritional factors present in plant-derived alternate fish feed ingredients and their effects in fish. Aquaculture 2001, 199, 197–227. [Google Scholar] [CrossRef]
- Irakli, M.; Lazaridou, A.; Biliaderis, C.G. Comparative evaluation of the nutritional, antinutritional, functional, and bioactivity attributes of rice bran stabilized by different heat treatments. Foods 2020, 10, 57. [Google Scholar] [CrossRef]
- Kokou, F.; Fountoulaki, E. Aquaculture waste production associated with antinutrient presence in common fish feed plant ingredients. Aquaculture 2018, 495, 295–310. [Google Scholar] [CrossRef]
- Koukoubani, T.; Makris, D.; Daniil, Z.; Paraforou, T.; Tsolaki, V.; Zakynthinos, E.; Papanikolaou, J. The role of antimicrobial resistance on long-term mortality and quality of life in critically ill patients: A prospective longitudinal 2-year study. Health Qual. Life Outcomes 2021, 19, 72. [Google Scholar] [CrossRef] [PubMed]
- Maisak, H.; Jantrakajorn, S.; Lukkana, M.; Wongtavatchai, J. Antibacterial activity of tannin from sweet chestnut wood against Aeromonas and Streptococcal pathogens of tilapia (Oreochromis niloticus). Thai J. Vet. Med. 2013, 43, 105–111. [Google Scholar] [CrossRef]
- Thitichayaphong, N.; Rukkwamsuk, T. Dietary supplementation of condensed tannin decreased lipid peroxidation in muscle of nile tilapias (Oreochromis niloticus). Thai J. Vet. Med. 2016, 46, 649–654. [Google Scholar] [CrossRef]
- Buyukcapar, H.; Atalay, A.; Kamalak, A. Growth performance of Nile tilapia (Oreochromis niloticus) fed with diets containing different levels of hydrolysable and condensed tannin. J. Agric. Sci. Technol. 2011, 13, 1045–1051. [Google Scholar]
- Maitra, S.; Ray, A. Inhibition of digestive enzymes in rohu, Labeo rohita (Hamilton), fingerlings by tannin: An in vitro study. Aquac. Res. 2003, 34, 93–95. [Google Scholar] [CrossRef]
- Talukdar, S.; Ringø, E.; Ghosh, K. Extracellular tannase-producing bacteria detected in the digestive tracts of freshwater fishes (Actinopterygii: Cyprinidae and Cichlidae). Acta Ichthyol. Piscat. 2016, 45, 373–384. [Google Scholar] [CrossRef]
- von Danwitz, A.; Schulz, C. Effects of dietary rapeseed glucosinolates, sinapic acid and phytic acid on feed intake, growth performance and fish health in turbot (Psetta maxima L.). Aquaculture 2020, 516, 734624. [Google Scholar] [CrossRef]

| Bacillus Strains | Antimicrobial Zone of Inhibition (mm) | |
|---|---|---|
| A. Hydrophila | S. Agalactiae | |
| K2.1 | 17.7 ± 0.21 d | 18.2 ± 0.28 d |
| K6.1 | 17.3 ± 0.35 d | 19.8 ± 0.28 c |
| K7.1 | 19.5 ± 0.71 b | 20.3 ± 0.35 bc |
| K9.1 | 18.1 ± 0.14 cd | 10.5 ± 0.71 h |
| K10.3 | 12.3 ± 0.28 f | 8.0 ± 0.10 i |
| K10.4 | 12.2 ± 0.28 f | 6.8 ± 0.35 j |
| K13.3 | 6.6 ± 0.57 k | 12.7 ± 0.42 g |
| K14.4 | 7.6 ± 0.07 j | 21.5 ± 0.71 ab |
| K15.2 | 6.3 ± 0.35 k | 17.8 ± 0.35 d |
| K15.4 | 15.7 ± 0.28 e | 20.9 ± 0.14 abc |
| K16.4 | 7.9 ± 0.50 ij | 15.6 ± 0.64 e |
| K18.3 | 8.9 ± 0.21 hi | 14.3 ± 0.35 f |
| K19.1 | 9.3 ± 0.35 gh | 21.8 ± 0.28 a |
| K21.3 | 10.3 ± 0.42 g | 6.7 ± 0.50 j |
| K22.6 | 18.9 ± 0.21 bc | 17.1 ± 0.42 d |
| K27.2 | 20.6 ± 0.50 a | 8.2 ± 0.21 i |
| K29.2 | 20.1 ± 0.28 bc | 18.3 ± 0.42 d |
| Bacillus Strains | Survival Rate (%) | ||
|---|---|---|---|
| pH 2 | pH 3 | Bile Salt 0.3% | |
| K2.1 | 28.3 ± 1.16 def | 54.7 ± 1.00 e | 90.4 ± 1.53 bc |
| K6.1 | 30.6 ± 3.00 de | 56.7 ± 0.58 e | 93.3 ± 2.31 abc |
| K7.1 | 28.9 ± 3.51 def | 44.8 ± 3.61 gh | 94.0 ± 1.00 ab |
| K9.1 | 25.5 ± 2.43 efg | 41.5 ± 1.59 h | 92.4 ± 2.31 abc |
| K10.3 | 20.9 ± 0.98 fg | 53.8 ± 2.11 ef | 88.1 ± 3.94 bc |
| K10.4 | 24.3 ± 3.07 efg | 56.7 ± 3.44 e | 86.1 ± 2.71 c |
| K13.3 | 31.6 ± 1.57 de | 60.3 ± 2.57 de | 90.4 ± 1.97 bc |
| K14.4 | 18.8 ± 2.49 g | 46.7 ± 3.05 gh | 87.3 ± 3.42 bc |
| K15.2 | 40.4 ± 2.27 c | 65.2 ± 2.83 cde | 94.2 ± 2.45 ab |
| K15.4 | 64.7 ± 4.73 ab | 72.7 ± 1.16 b | 99.0 ± 0.58 a |
| K16.4 | 29.5 ± 4.73 de | 52.1 ± 2.43 f | 90.2 ± 2.31 bc |
| K18.3 | 25.9 ± 3.22 efg | 40.6 ± 1.89 h | 85.9 ± 2.73 c |
| K19.1 | 30.0 ± 2.46 de | 44.0 ± 2.01 gh | 88.8 ± 2.06 bc |
| K21.3 | 36.1 ± 1.77 cd | 50.5 ± 1.39 fg | 89.6 ± 3.03 bc |
| K22.6 | 64.3 ± 1.00 b | 71.4 ± 2.08 bc | 90.3 ± 3.05 bc |
| K27.2 | 31.1 ± 2.88 de | 52.5 ± 4.01 f | 91.4 ± 3.95 abc |
| K29.2 | 72.9 ± 2.52 a | 80.9 ± 2.00 a | 98.4 ± 0.58 a |
| Bacillus Strains | Closest Species | Similarity (%) | Nucleotide (bp) | Accession Number |
|---|---|---|---|---|
| K2.1 | B. tequilensis KCTC 13622 | 99.93 | 1449 | OR534569 |
| K6.1 | B. tequilensis KCTC 13622 | 99.93 | 1449 | OR534570 |
| K7.1 | B. tequilensis KCTC 13622 | 100.00 | 1450 | OR534571 |
| K15.4 | B. tequilensis KCTC 13622 | 99.59 | 1460 | OR534572 |
| K22.6 | B. tequilensis KCTC 13622 | 99.93 | 1450 | OR534573 |
| K29.2 | B. siamensis KCTC 13613 | 99.93 | 1459 | OR534574 |
| Antibiotics in 10 µg/mL | Antibiotics Inhibitory Zone Diameter (mm) | |||||
|---|---|---|---|---|---|---|
| K2.1 | K6.1 | K7.1 | K15.4 | K22.6 | K29.2 | |
| Erythromycin | 31.5 ± 2.10 b | 34.5 ± 0.70 a | 30.5 ± 0.70 b | 32.0 ± 1.40 b | 29.5 ± 0.70 b | 31.0 ± 1.40 b |
| Chloramphenicol | 33.5 ± 0.70 a | 35.0 ± 1.40 a | 29.0 ± 1.00 b | 26.5 ± 0.70 c | 30.3 ± 1.00 b | 29.8 ± 0.30 b |
| Streptomycin | 17.3 ± 1.10 b | 9.3 ± 0.40 c | 10.5 ± 0.70 c | 8.3 ± 1.10 c | 15.0 ± 3.00 b | 22.8 ± 1.10 a |
| Kanamycin | 24.5 ± 0.70 a | 25.8 ± 0.40 a | 11.5 ± 0.07 d | 14.3 ± 0.40 c | 22.9 ± 1.20 b | 25.8 ± 0.40 a |
| Ampicillin | 29.0 ± 1.40 b | 37.0 ± 1.40 a | 25.5 ± 0.70 c | 9.5 ± 2.10 d | 30.5 ± 0.70 b | 30.0 ± 1.40 b |
Disclaimer/Publisher’s Note: The statements, opinions and data contained in all publications are solely those of the individual author(s) and contributor(s) and not of MDPI and/or the editor(s). MDPI and/or the editor(s) disclaim responsibility for any injury to people or property resulting from any ideas, methods, instructions or products referred to in the content. |
© 2024 by the authors. Licensee MDPI, Basel, Switzerland. This article is an open access article distributed under the terms and conditions of the Creative Commons Attribution (CC BY) license (https://creativecommons.org/licenses/by/4.0/).
Share and Cite
Anyairo, C.S.; Unban, K.; Wongputtisin, P.; Rojtinnakorn, J.; Shetty, K.; Khanongnuch, C. Bacillus spp. Isolated from Miang as Potential Probiotics in Nile Tilapia Culture—In Vitro Research. Microorganisms 2024, 12, 1687. https://doi.org/10.3390/microorganisms12081687
Anyairo CS, Unban K, Wongputtisin P, Rojtinnakorn J, Shetty K, Khanongnuch C. Bacillus spp. Isolated from Miang as Potential Probiotics in Nile Tilapia Culture—In Vitro Research. Microorganisms. 2024; 12(8):1687. https://doi.org/10.3390/microorganisms12081687
Chicago/Turabian StyleAnyairo, Chioma Stella, Kridsada Unban, Pairote Wongputtisin, Jiraporn Rojtinnakorn, Kalidas Shetty, and Chartchai Khanongnuch. 2024. "Bacillus spp. Isolated from Miang as Potential Probiotics in Nile Tilapia Culture—In Vitro Research" Microorganisms 12, no. 8: 1687. https://doi.org/10.3390/microorganisms12081687
APA StyleAnyairo, C. S., Unban, K., Wongputtisin, P., Rojtinnakorn, J., Shetty, K., & Khanongnuch, C. (2024). Bacillus spp. Isolated from Miang as Potential Probiotics in Nile Tilapia Culture—In Vitro Research. Microorganisms, 12(8), 1687. https://doi.org/10.3390/microorganisms12081687

